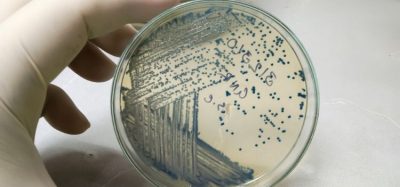
L-DOPA terephthalic acid

Vinay Prasad to exit CBER as FDA group director
By Catherine Eckford (European Pharmaceutical Review)
CSL breaks ground on $1.5bn Illinois plasma therapy facility expansion
By Catherine Eckford (European Pharmaceutical Review)
Biogen/Stoke’s zorevunersen hailed as potential first disease-modifying drug for rare epilepsy
By Catherine Eckford (European Pharmaceutical Review)
Sanofi gains access to first-in-class JAK inhibitor through $1.5bn licensing deal
By Catherine Eckford (European Pharmaceutical Review)
Applying AI to enhance drug formulation and development
By Sanjay Konagurthu (Thermo Fisher Scientific)
Accelerating consistent, stable cell line development with targeted integration
By Fei Chen (WuXi Biologics), Hang Zhou (WuXi Biologics), Tao…